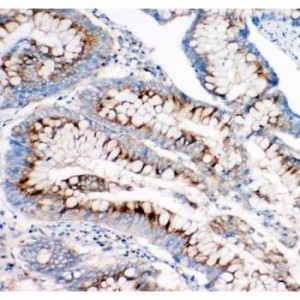
Mannose 6 Phosphate Receptor(Cation independent) Antibody

Immunohistochemistry (IHC)
Showing 433–444 of 1068 resultsSorted by latest
-

MAP Kinase, Activated(Diphosphorylated ERK-1&2) Antibody (monoclonal)
$330.00 Add to cart -

MAOA Antibody
$365.00 Add to cart -
Mannose 6 Phosphate Receptor(Cation independent) Antibody
$330.00 Add to cart -

MAG Antibody
$330.00 Add to cart -

MADH7 Antibody
$330.00 Add to cart -

MAdCAM1 Antibody
$330.00 Add to cart -

MAD1 Antibody
$365.00 Add to cart -

Lysozyme Antibody
$365.00 Add to cart -

LYRIC Antibody
$365.00 Add to cart -

Lymphotactin Antibody
$330.00 Add to cart -

Lumican Antibody
$365.00 Add to cart -

LTBR Antibody
$330.00 Add to cart